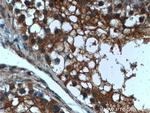
LIPI Antibody in Immunohistochemistry (Paraffin) (IHC (P))

Search
Proteintech
LIPI Polyclonal Antibody
{{$productOrderCtrl.translations['antibody.pdp.commerceCard.promotion.promotions']}}
{{$productOrderCtrl.translations['antibody.pdp.commerceCard.promotion.viewpromo']}}
{{$productOrderCtrl.translations['antibody.pdp.commerceCard.promotion.promocode']}}: {{promo.promoCode}} {{promo.promoTitle}} {{promo.promoDescription}}. {{$productOrderCtrl.translations['antibody.pdp.commerceCard.promotion.learnmore']}}
产品信息
24300-1-AP
种属反应
宿主/亚型
分类
类型
抗原
偶联物
形式
浓度
规格
纯化类型
保存液
内含物
保存条件
运输条件
产品详细信息
Immunogen sequence: FSGIQFIKC NHQRAVHLFM ASLETNCNFI SFPCRSYKDY KTSLCVDCDC FKEKSCPRLG YQAKLFKGVL KERMEGRPLR TTVFLDTSGT YPFCTYYFVL SIIVPDKTMM DGSFSFKLLN QLGMIEEPRL YEKNKPFYKL QEVKILAQFY NDFVNISSIG LTYFQSSNLQ CSTCTYKIQR LMLKSLTYPE RPPLCRYNIV LKDREEVFLN PNTCTPKNT (264-481 aa encoded by BC148691)
靶标信息
Hydrolyzes specifically phosphatidic acid (PA) to produce 2-acyl lysophosphatidic acid (LPA; a potent bioactive lipid mediator) and fatty acid. Does not hydrolyze other phospholipids, like phosphatidylserine (PS), phosphatidylcholine (PC) and phosphatidylethanolamine (PE) or triacylglycerol (TG).
仅用于科研。不用于诊断过程。未经明确授权不得转售。
篇参考文献 (0)
生物信息学
蛋白别名: Cancer/testis antigen 17; CT17; lipase; Lipase member I; lipase, member I; LIPI; LPD lipase; Membrane-associated phosphatidic acid-selective phospholipase A1-beta; mPA-PLA1 beta
基因别名: CT17; D930038D03Rik; LIPI; lpd1; LPDL; mPA-PLA1 beta; PLA1C; PRED5
UniProt ID: (Human) Q6XZB0
Entrez Gene ID: (Human) 149998, (Mouse) 320355